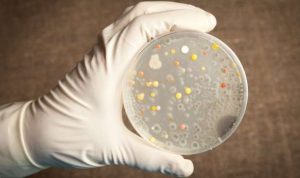

Perut buncit sering kali menjadi masalah yang mengganggu penampilan dan kepercayaan diri. Tidak hanya itu, penumpukan lemak di perut juga berisiko menimbulkan berbagai penyakit, mulai dari gangguan metabolisme hingga masalah jantung. Salah satu faktor yang paling berpengaruh adalah pola makan. Beberapa jenis makanan ternyata bisa memicu penimbunan lemak dan membuat perut tampak lebih besar. Karena itu, penting untuk mengetahui apa saja makanan yang sebaiknya dihindari agar perut tetap rata dan sehat.
Salah satu penyebab utama perut buncit adalah konsumsi makanan tinggi gula. Minuman manis, kue, permen, dan camilan kemasan biasanya mengandung gula berlebih yang mudah berubah menjadi lemak di dalam tubuh. Gula sederhana yang dikonsumsi secara berlebihan juga dapat meningkatkan kadar insulin, yang pada akhirnya mendorong tubuh menyimpan lebih banyak lemak, terutama di area perut.
Selain gula, makanan tinggi karbohidrat olahan juga menjadi pemicu utama. Nasi putih, roti tawar, mie instan, dan makanan cepat saji mengandung karbohidrat sederhana yang cepat dicerna tubuh, tetapi membuat rasa kenyang hanya bertahan sebentar. Hal ini sering mendorong seseorang makan lebih banyak dan akhirnya memperbesar risiko penumpukan lemak.
Makanan berlemak jenuh, seperti gorengan, daging berlemak tinggi, serta produk olahan seperti sosis dan nugget juga berkontribusi pada pembesaran perut. Lemak jenuh tidak hanya menambah kalori berlebih, tetapi juga bisa memicu peradangan dalam tubuh yang memperlambat metabolisme. Akibatnya, lemak lebih mudah tersimpan dan sulit dibakar.
Perut buncit juga bisa dipicu oleh konsumsi minuman berkarbonasi atau bersoda. Gas dalam minuman ini dapat menimbulkan kembung, sementara kadar gula dan kalori tinggi yang terkandung di dalamnya memperbesar risiko obesitas. Begitu pula dengan konsumsi alkohol berlebihan, yang dikenal sebagai penyebab utama beer belly atau perut buncit khas peminum alkohol.
Tidak hanya makanan berat, camilan asin juga perlu diwaspadai. Makanan dengan kadar garam tinggi membuat tubuh menahan lebih banyak cairan, sehingga perut tampak membesar akibat retensi air. Keripik, makanan kalengan, hingga saus instan adalah contoh sumber natrium tinggi yang sebaiknya dikurangi.
Menghindari makanan pemicu perut buncit saja tentu tidak cukup. Pola makan sehat tetap harus diterapkan dengan memperbanyak konsumsi sayuran, buah, biji-bijian utuh, serta protein tanpa lemak. Selain itu, kebiasaan makan teratur dengan porsi seimbang juga membantu metabolisme tetap optimal. Aktivitas fisik, seperti olahraga rutin dan latihan otot perut, menjadi pelengkap penting agar usaha menjaga bentuk tubuh lebih efektif.
Pada akhirnya, menjaga perut agar tidak buncit bukan hanya soal penampilan, melainkan juga soal kesehatan. Dengan menghindari makanan tinggi gula, karbohidrat olahan, lemak jenuh, minuman bersoda, dan makanan tinggi garam, serta menggantinya dengan pilihan yang lebih sehat, tubuh akan terasa lebih ringan, bugar, dan terhindar dari risiko penyakit berbahaya.